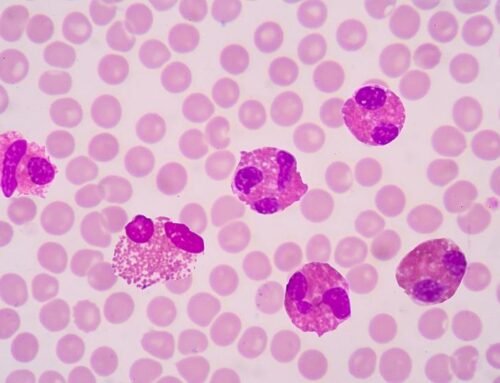
Eozinofilik kolit nedenleri nelerdir?

Eozinofilik kolit belirtileri olan çocuk ve yetişkinlerde kolonoskopi yapılmalıdır. Kolonoskopi ile tanı konulmaktadır. Kolondan alınan biyopsilerde 20/hba dann fazla eozinofil görülmesi tanıyı destekler. Kanda eozinofili görülebilmektedir. Diğer eozinofili ile giden hastalıklara göre kusmadan ziyade ishalin ön planda olduğu, kanlı kakanın görülebildiği, bebeklerde daha sık görülen, alerjik hastalıklarla birlikte olan; genellikle diyetten fayda sağlanabildiği ve kesin teşhisi kolonoskopi ile yapılabildiği besin alerjisi tablosudur. Ancak ayırıcı tanıda; Crohn, ülseratif kolit gibi bağırsak hastalıkları, lupus, skleroderma, dermatomiyozit gibi kollajen doku hastalıklar, parazit enfeksiyonları, vaskülitler ve ilaç reaksiyonları da akla gelmelidir.